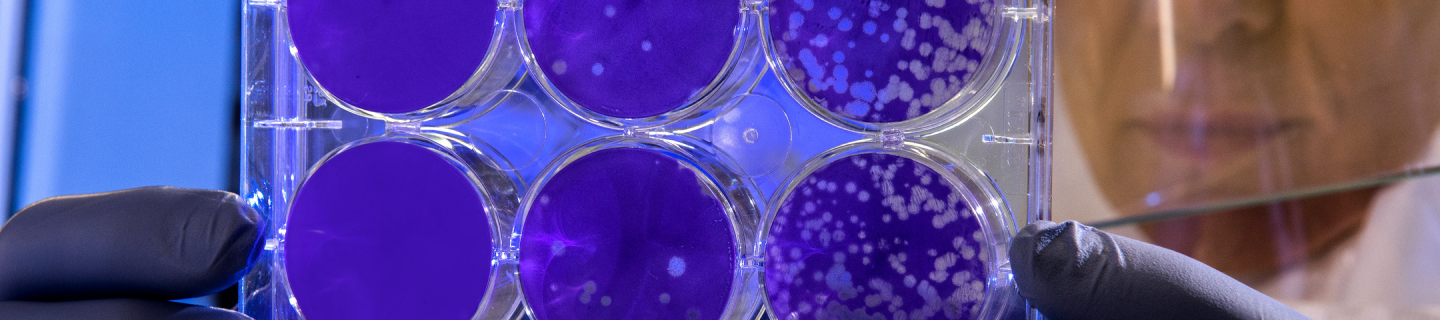

100+
PROJECTS DELIVERED
Most took years
98%
REFERRALS
Most recommend us
2-3
YEARS
Average partnership time
Insights and technology to inspire a better healthcare system
Our experts provide tailor-made solutions for
your business in the following areas
your business in the following areas
Build a software architecture in R&D, production, circulation, consumption and other links, open up the Internet access between
medical research and health management, and shorten the distance between medical research and people's health.
medical research and health management, and shorten the distance between medical research and people's health.
Technology Strategy, Operations and Software Services
While the business of healthcare companies is primarily focused on research and development activities and funding of clinical trials, the commercialization of the market requires companies to focus on developing IT systems and infrastructure to ensure they mature and meet demand. Based on this, our team will help companies develop a roadmap and ensure a successful implementation.
Internet Security and Privacy Services
As more systems migrate to virtual environments, cyber threats and liability risks increase. We help companies establish comprehensive cybersecurity strategies to protect intellectual property, clinical trial data, employee data, and patient information from theft or misuse.
Laboratory Management System
From the five dimensions of "human, machine, material, method, and environment", integrate data information such as laboratory equipment, consumables, testing method standards, and quality management, and conduct comprehensive analysis and management of digital information to realize paperless laboratories office.
Telemedicine Solutions
Through remote consultation, video first aid, medical training and other scenarios, more communication bridges between patients and doctors, and between doctors and doctors will be established to promote the development of online medical care and help the balanced distribution of medical resources.
Doctor-patient Interaction Platform
Focusing on patients, from the original product sales, gradually shifting to providing valuable services to patients by improving the treatment effect, realizing functions such as online follow-up consultation, doctor-patient interaction, health follow-up, and medical professional information inquiry.
Medical Internet of Things
Using the Internet of Things technology, through the comprehensive application of wireless communication, sensors, RFID, video detection and identification and other technologies in the entire medical management system, in order to realize intelligent identification, positioning, tracking, monitoring and management, and establish a real-time, accurate and efficient medical control and management system.
Insights and technology to inspire a better healthcare system
The value we can bring to you
Combining Internet of Things technology, intelligent mobile Internet technology, cloud computing, etc., combined with the industry's own characteristics, to solve the pain points of the existing industry, realize on-demand response, create a new and reasonable allocation of enterprise resources
Managed IT Support
When we say managed IT services, we mean comprehensive IT support and management systems designed to help you manage your IT infrastructure. We provide you with advanced monitoring of your IT systems, provide preventive maintenance to ensure all your systems are running as planned, we provide unlimited phone support and remote support, you can contact us anytime. We make it easier for you to run your IT infrastructure and systems like an in-house IT department.
Exclusive function customization
Help develop customer relationships, sort out sales management processes, rationally allocate corporate resources, upgrade corporate management quality, and comprehensively enhance core competitiveness!
Multi-terminal synchronous
coordination operation
coordination operation
Build a paperless OA, CRM, and ERP system with clear layers, multi-terminal synchronization, and collaborative operation, and support WEB+PC+APP+WeChat full-channel and full-network development.
100% source code delivery
The delivery of all source codes provides the greatest convenience and scalability for secondary development and system integration, and the use value of high-efficiency development, low-cost maintenance, and sustainable improvement of management.
Free Assessment Needs
Starting from the needs of the enterprise, provide solutions, make quotation documents, and obtain the quotation plan in 30 minutes.
CASE STUDY
CASE STUDY
In the world, more and more CTOs recommend our talent for custom
software projects
OUR CLIENT
An online medical system platform that provides consultation and shopping mall services
GOALS
Serving 50,000+ member users, 1000+ physicians and nutritionists, equipped with member points management system
AI intelligent health consultation, improving the accuracy of physician consultation,
improving membership upgrade rate, repurchase rate, and loyalty

We reduced maintenance and operational costs
from $200,000 to $50,000!

75% saved
Intelligent consultation system


Inquire in detail to avoid ignoring key information about symptoms.

Inquiry, nursing and treatment recommendations, etc., each step has intelligent guidance.

Physicians can upload medical records to help other physicians make quick decisions in the future.
Technologies we work with

ios

Android

React native

Flutter

Ionic

Swift

Kotlin

Objectivec

Angular.js

React js

Typescript

Vue

Wpf

Html5

Mongo db

Mysql

Mssql

Firebase

DynamoDB

Redis

Php

Java

Node.JS

Wordpress

Magento

Shopify

AWS

Gradle

Jenkins

Appium

Selenium

Azure

Digital ocean

Rackspace

Linode
Key Highlights
our work in numbers.
Build your web presence to thrive just like many others have, and let
experienced technicians and digital creators develop functionalities
that rivet your target audience.
10+
Years
100+
Employees
300+
Projects
200+
Clients
10 years of building digital products and we are just getting started!
We are different in 3 aspects

We are not here to charge an hourly rate
We are not here to charge an hourly rate
We are not just designers and developer
The team worked in product, operation, marketing and all aspects of
a business, we make sure our works are tailored to your business
model and operations.
We are not hiding our expertise
We are not hiding our expertise, we think our client would benefit
if we share our thoughts, rationales, facts and data with them. It
is our principle of work.
Technologies Partner







Contact
Want to talk about your project ?
Let’s get in touch with us. We would love to hear from you.

Contact us








